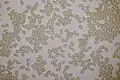
Sporen

Tweekleurige vaalhoed
| Tweekleurige vaalhoed | |||||||||||||||
|---|---|---|---|---|---|---|---|---|---|---|---|---|---|---|---|

| |||||||||||||||
| Taxonomische indeling | |||||||||||||||
| |||||||||||||||
| Soort | |||||||||||||||
| Hebeloma mesophaeum (Pers.) Quél. (1872 [1]) | |||||||||||||||
| Afbeeldingen op | |||||||||||||||
| |||||||||||||||
De tweekleurige vaalhoed (Hebeloma mesophaeum) is een schimmel in de familie Hymenogastraceae. Hij vormt ectomycorrhiza met loof- en naaldbomen zoals berk (Betula), eik (Quercus), Fagus, den (Pinus) en fijnspar (Picea). Vaak komt hij voor bij jonge boompjes op humusarm zand of zandige leem. Hij is ook gevonden bij linde (Tilia) en Corylus in loofbossen en lanen op voedselrijke klei of leem en ten slotte in struwelen van kruipwilg (Salix repens) op droog, humusarm zand.[2] De vruchtlichamen verschijnen van september tot november op min of meer vochtige grond. Op sommige plaatsen komt hij in grote aantallen voor.
Kenmerken
Uiterlijke kenmerken
- Hoed
De hoed is 5 tot 8 cm in diameter. De vorm is halfbolvormig tot vlak gewelfd. Het hoedoppervlak is typisch tweekleurig. De kleur is midden roodachtig tot kastanjebruin en vettig, de rand is licht crème-beige en fijnkorrelig. Bij droog weer is het oppervlak van de hoed glad, droog en mat, bij nat weer glad, plakkerig en glanzend. Bovendien is de hoedrand vaak versierd met resten van zilverachtig tot lichtgeel perkament. Jonge exemplaren hebben een duidelijk uitgesproken cortina. De hoed heeft geen kleurreactie met KOH.[3]
- Lamellen
De lamellen zijn overvol, breed, lichter of donkerder melkachtig koffiekleurig en uitpuilend op de steel.
- Steel
De steel is 5 tot 10 cm lang en 0,5 tot 0,8 cm breed. Op een bleke houtbruine achtergrond en steeds donkerder wordend naar de basis van de steel toe, is het pluizig viltig vanwege de grijs-witachtige, afveegbare cortina.
- Geur en smaak
Het vruchtvlees is min of meer dezelfde kleur. Het ruikt licht radijsachtig of fruitig en smaakt bitter.
- Sporenprint
De sporenprint is bruin.
Microscopische kenmerken
De eivormige tot ellipsvormige, bijna gladde sporen meten 7,3 - 10,5 × 4,6–6,6 μm met een Q-getal van gemiddeld 1,34 tot 1,86. Ze zijn fijn geornamenteerd met wratten. De basidia meten (18) 20–34 (43) × (4) 5–9 (10) μm met een Q-getal van 3,1 tot 4,4. De cheilocystidia hebben de vorm lageniform (flesvormig) of ventricose, soms cilindrisch, zelden clavaat of lentiform. Ze zijn 26 tot 62 μm lang, 5,8 tot 11,0 μm breed aan de basis en 3,5–6,1 μm breed aan de top. Pleurocystidia zijn meestal niet aanwezig, indien wel dan dicht bij de lamelsnede.[4]
Verspreiding
De tweekleurige vaalhoed komt voor in Noord-, Midden- en Zuid-Amerika, Europa, Azië en Nieuw-Zeeland. In Nederland komt hij zeer algemeen voor.
Naam
De soortnaam komt uit het Grieks: meso betekent het midden en phaeus betekent donker gekleurd.
Foto's
-
_Figure_16.jpg) Montage met sporen en cheilocystidia
Montage met sporen en cheilocystidia -
Sporen
Sporen -
 Cheilocystidia
Cheilocystidia -
 Cheilocystidia
Cheilocystidia -
 Basidia
Basidia -
 Lamellen
Lamellen
Trivia
De odeurzwam parasiteert op de tweekleurige vaalhoed.[5]